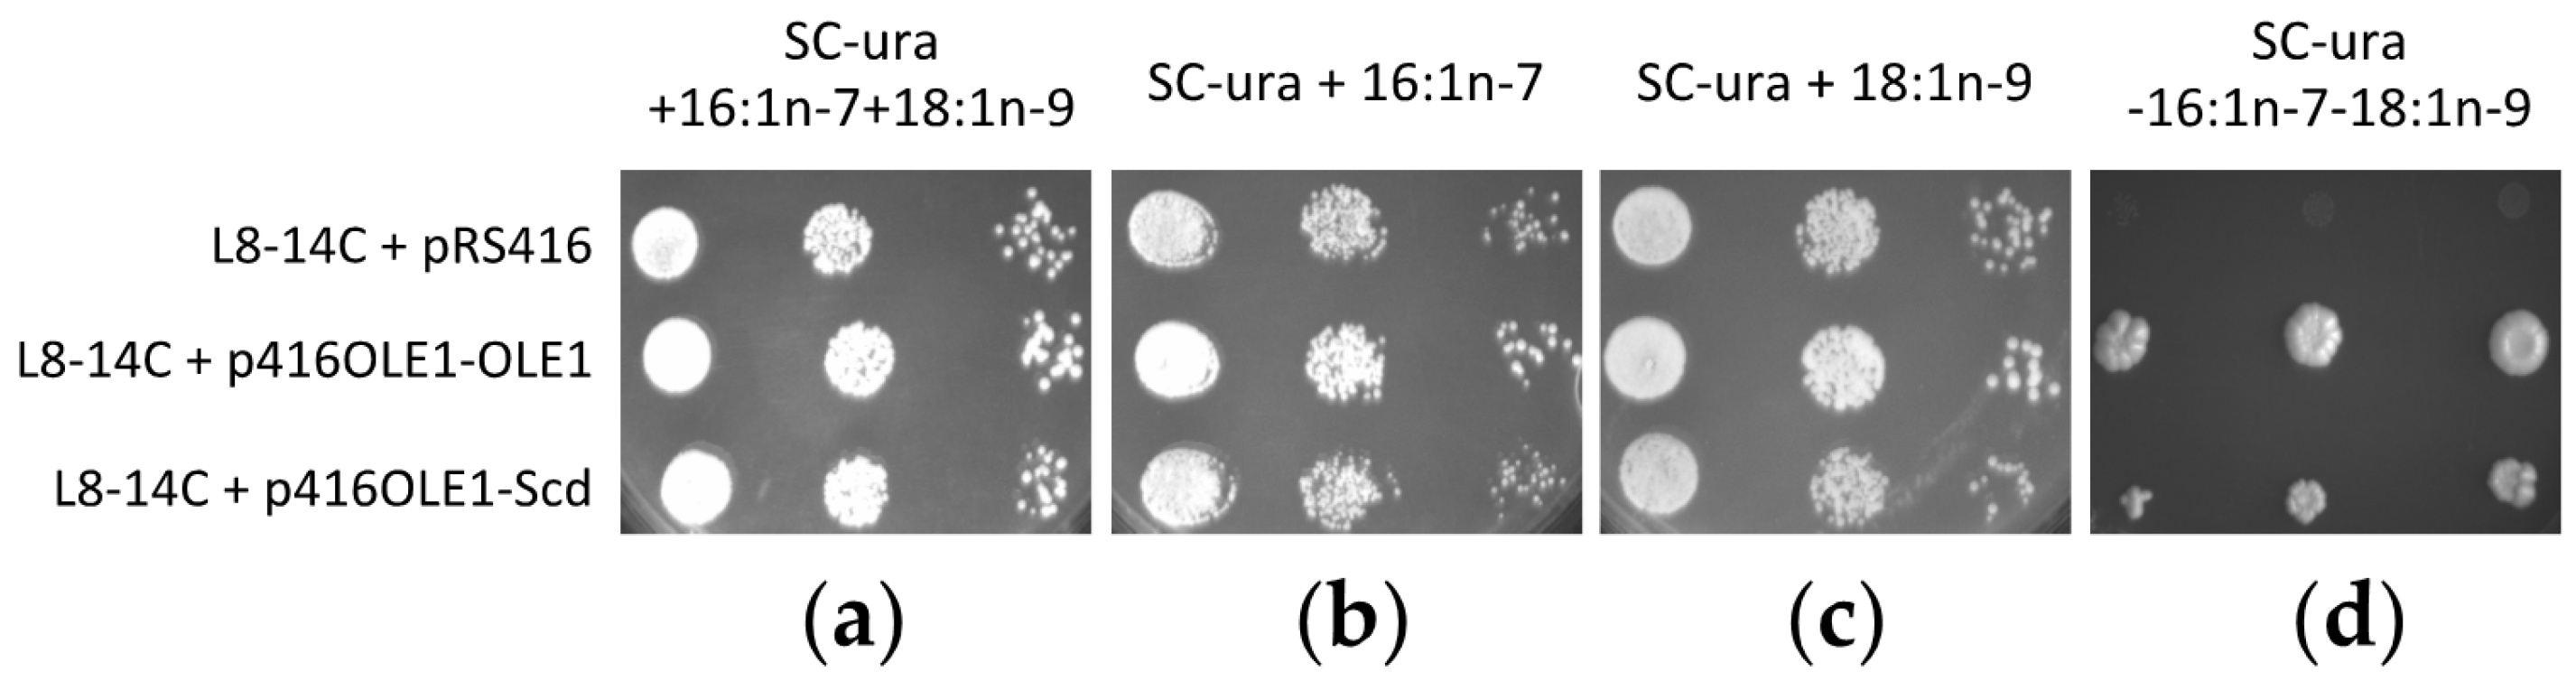

Biosynthesis of Polyunsaturated Fatty Acids in Octopus vulgaris: Molecular Cloning and Functional Characterisation of a Stearoyl-CoA Desaturase and an Elongation of Very Long-Chain Fatty Acid 4 Protein
Abstract
:1. Introduction
2. Results
2.1. Octopus vulgaris Scd Sequence
2.2. Octopus Elovl4-Like Sequence
2.3. Functional Characterisation of the Octopus Scd
2.4. Functional Characterisation of the Octopus Elovl4
3. Discussion
4. Materials and Methods
4.1. Tissue Samples
4.2. Molecular Cloning of the Scd and Elovl4 cDNA Sequences
4.3. Sequence Analysis
4.4. Functional Characterisation of Octopus Scd: Complementation Assay of the S. cerevisiae ole1∆ Mutant Strain L8-14C
4.5. Functional Characterisation of Octopus Scd: Overexpression in the S. cerevisiae Strain InvSc1
4.6. Role of the Octopus Scd and Δ5 Fad in the Biosynthesis of Non-Methylene-Interrupted FAs
4.7. Functional Characterisation of Octopus Elovl4: Expression in the S. cerevisiae Strain InvSc1
4.8. Fatty Acid Analysis by GC-MS
4.9. Statistical Analyses
4.10. Materials
Supplementary Materials
Acknowledgments
Author Contributions
Conflicts of Interest
References
- Iglesias, J.; Fuentes, L.; Villanueva, R. Cephalopod Culture; Springer: Dordrecht, The Netherlands, 2014; p. 494. [Google Scholar]
- Iglesias, J.; Sánchez, F.J.; Bersano, J.G.F.; Carrasco, J.F.; Dhont, J.; Fuentes, L.; Linares, F.; Muñoz, J.L.; Okumura, S.; Roo, J.; et al. Rearing of Octopus vulgaris paralarvae: Present status, bottlenecks and trends. Aquaculture 2007, 266, 1–15. [Google Scholar] [CrossRef]
- Navarro, J.C.; Monroig, Ó.; Sykes, A.V. Nutrition as a key factor for cephalopod aquaculture. In Cephalopod Culture; Iglesias, J., Fuentes, L., Villanueva, R., Eds.; Springer: Dordrecht, The Netherlands, 2014; pp. 77–96. [Google Scholar]
- Navarro, J.C.; Villanueva, R. Lipid and fatty acid composition of early stages of cephalopods: An approach to their lipid requirements. Aquaculture 2000, 183, 161–177. [Google Scholar] [CrossRef]
- Navarro, J.C.; Villanueva, R. The fatty acid composition of Octopus vulgaris paralarvae reared with live and inert food: Deviation from their natural fatty acid profile. Aquaculture 2003, 219, 613–631. [Google Scholar] [CrossRef]
- Monroig, Ó.; Navarro, J.C.; Dick, J.R.; Alemany, F.; Tocher, D.R. Identification of a Δ5-like fatty acyl desaturase from the cephalopod Octopus vulgaris (Cuvier 1797) involved in the biosynthesis of essential fatty acids. Mar. Biotechnol. 2012, 14, 411–422. [Google Scholar] [CrossRef] [PubMed]
- Guillou, H.; Zadravec, D.; Martin, P.G.P.; Jacobsson, A. The key roles of elongases and desaturases in mammalian fatty acid metabolism: Insights from transgenic mice. Prog. Lipid Res. 2010, 49, 186–199. [Google Scholar] [CrossRef] [PubMed]
- Monroig, Ó.; Navarro, J.C.; Tocher, D.R. Long-chain polyunsaturated fatty acids in fish: Recent advances on desaturases and elongases involved in their biosynthesis. In Proceedings of the XI International Symposium on Aquaculture Nutrition; Cruz-Suarez, L.E., Ricque-Marie, D., Tapia-Salazar, M., Nieto-López, M.G., Villarreal-Cavazos, D.A., Gamboa-Delgado, J., Hernández-Hernández, L.H., Eds.; Universidad Autónoma de Nuevo León: Monterrey, Mexico, 2011; pp. 257–282. [Google Scholar]
- Castro, L.F.C.; Tocher, D.R.; Monroig, O. Long-chain polyunsaturated fatty acid biosynthesis in chordates: Insights into the evolution of Fads and Elovl gene repertoire. Prog. Lipid Res. 2016, 62, 25–40. [Google Scholar] [CrossRef] [PubMed]
- Monroig, Ó.; Guinot, D.; Hontoria, F.; Tocher, D.R.; Navarro, J.C. Biosynthesis of essential fatty acids in Octopus vulgaris (Cuvier, 1797): Molecular cloning, functional characterisation and tissue distribution of a fatty acyl elongase. Aquaculture 2012, 360–361, 45–53. [Google Scholar] [CrossRef]
- Monroig, Ó.; Tocher, D.R.; Navarro, J.C. Biosynthesis of polyunsaturated fatty acids in marine invertebrates: Recent advances in molecular mechanisms. Mar. Drugs 2013, 11, 3998–4018. [Google Scholar] [CrossRef] [PubMed]
- Liu, H.; Zheng, H.; Wang, S.; Wang, Y.; Li, S.; Liu, W.; Zhang, G. Cloning and functional characterization of a polyunsaturated fatty acid elongase in a marine bivalve noble scallop Chlamys nobilis Reeve. Aquaculture 2013, 416, 146–151. [Google Scholar] [CrossRef]
- Monroig, Ó.; Lopes-Marques, M.; Navarro, J.C.; Hontoria, F.; Ruivo, R.; Santos, M.M.; Venkatesh, B.; Tocher, D.R.; Castro, L.F.C. Evolutionary wiring of the polyunsaturated fatty acid biosynthetic pathway. Sci. Rep. 2016, 6, 20510. [Google Scholar] [CrossRef] [PubMed]
- Sprecher, H. Metabolism of highly unsaturated n-3 and n-6 fatty acids. Biochim. Biophys. Acta 2000, 1486, 219–231. [Google Scholar] [CrossRef]
- Monroig, Ó.; Rotllant, J.; Cerdá-Reverter, J.M.; Dick, J.R.; Figueras, A.; Tocher, D.R. Expression and role of Elovl4 elongases in biosynthesis of very long-chain fatty acids during zebrafish Danio rerio early embryonic development. Biochim. Biophys. Acta 2010, 1801, 1145–1154. [Google Scholar] [CrossRef] [PubMed]
- Monroig, Ó.; Webb, K.; Ibarra-Castro, L.; Holt, G.J.; Tocher, D.R. Biosynthesis of long-chain polyunsaturated fatty acids in marine fish: Characterization of an Elovl4-like elongase from cobia Rachycentron canadum and activation of the pathway during early life stages. Aquaculture 2011, 312, 145–153. [Google Scholar] [CrossRef]
- Carmona-Antoñanzas, G.; Monroig, Ó.; Dick, J.R.; Davie, A.; Tocher, D.R. Biosynthesis of very long-chain fatty acids (C>24) in Atlantic salmon: Cloning, functional characterisation, and tissue distribution of an Elovl4 elongase. Comp. Biochem. Physiol. B 2011, 159, 122–129. [Google Scholar] [CrossRef] [PubMed]
- Monroig, Ó.; Wang, S.; Zhang, L.; You, C.; Tocher, D.R.; Li, Y. Elongation of long-chain fatty acids in rabbitfish Siganus canaliculatus: Cloning, functional characterisation and tissue distribution of Elovl5- and Elovl4-like elongases. Aquaculture 2012, 350–353, 63–70. [Google Scholar] [CrossRef]
- Li, S.; Monroig, Ó.; Navarro, J.C.; Yuan, Y.; Xu, W.; Mai, K.; Tocher, D.R.; Ai, Q. Molecular Cloning, functional characterization and nutritional regulation by dietary fatty acid profiles of a putative Elovl4 gene in orange-spotted grouper Epinephelus coioides. Aquac. Res. 2017, 48, 537–552. [Google Scholar] [CrossRef]
- Monroig, Ó.; Hontoria, F.; Varó, I.; Tocher, D.R.; Navarro, J.C. Investigating the essential fatty acids in the common cuttlefish Sepia officinalis (Mollusca, Cephalopoda): Molecular cloning and functional characterisation of fatty acyl desaturase and elongase. Aquaculture 2016, 450, 38–47. [Google Scholar] [CrossRef]
- Joseph, J.D. Lipid composition of marine and estuarine invertebrates. Part II: Mollusca. Prog. Lipid Res. 1982, 21, 109–153. [Google Scholar] [CrossRef]
- Barnathan, G. Non-methylene-interrupted fatty acids from marine invertebrates: Occurrence, characterization and biological properties. Biochimie 2009, 91, 671–678. [Google Scholar] [CrossRef] [PubMed]
- Kornprobst, J.M.; Barnathan, G. Demospongic acids revisited. Mar. Drugs 2010, 8, 2569–2577. [Google Scholar] [CrossRef] [PubMed]
- Castro, L.F.C.; Wilson, J.M.; Gonçalves, O.; Galante-Oliveira, S.; Rocha, E.; Cunha, I. The evolutionary history of the stearoyl-CoA desaturase gene family in vertebrates. BMC Evol. 2011, 11, 132. [Google Scholar] [CrossRef] [PubMed]
- Watts, J.L.; Browse, J. A palmitoyl-CoA-specific ∆9 fatty acid desaturase from Caenorhabditis elegans. Biochem. Biophys. Res. Commun. 2000, 272, 263–269. [Google Scholar] [CrossRef] [PubMed]
- Jakobsson, A.; Westerberg, R.; Jacobsson, A. Fatty acid elongases in mammals: Their regulation and roles in metabolism. Prog. Lipid Res. 2006, 45, 237–249. [Google Scholar] [CrossRef] [PubMed]
- Meyer, A.; Kirsch, H.; Domergue, F.; Abbadi, A.; Sperling, P.; Bauer, J.; Cirpus, P.; Zank, T.K.; Moreau, H.; Roscoe, T.J.; et al. Novel fatty acid elongases and their use for the reconstitution of docosahexaenoic acid biosynthesis. J. Lipid Res. 2004, 45, 1899–1909. [Google Scholar] [CrossRef] [PubMed]
- Stukey, J.; McDonough, V.; Martin, C. Isolation and characterization of OLE1, a gene affecting fatty acid desaturation from Saccharomyces cerevisiae. J. Biol. Chem. 1989, 264, 16537–16544. [Google Scholar] [PubMed]
- Porta, A.; Fortino, V.; Armenante, A.; Maresca, B. Cloning and characterization of a D9-desaturase gene of the Antarctic fish Chionodraco hamatus and Trematomus bernacchii. J. Comp. Physiol. B 2013, 183, 379–392. [Google Scholar] [CrossRef] [PubMed]
- Agaba, M.; Tocher, D.R.; Dickson, C.; Dick, J.R.; Teale, A.J. Zebrafish cDNA encoding multifunctional fatty acid elongase involved in production of eicosapentaenoic (20:5n-3) and docosahexaenoic (22:6n-3) acids. Mar. Biotechnol. 2004, 6, 251–261. [Google Scholar] [CrossRef] [PubMed]
- Bell, M.V.; Tocher, D.R. Biosynthesis of polyunsaturated fatty acids in aquatic ecosystems: General pathways and new directions. In Lipids in Aquatic Ecosystems; Arts, M.T., Brett, M., Kainz, M., Eds.; Springer: New York, NY, USA, 2009; pp. 211–236. [Google Scholar]
- Tocher, D.R. Omega-3 long-chain polyunsaturated fatty acids and aquaculture in perspective. Aquaculture 2015, 449, 94–107. [Google Scholar] [CrossRef]
- Reis, D.B.; Acosta, N.G.; Almansa, E.; Navarro, J.C.; Tocher, D.R.; Monroig, O.; Andrade, J.P.; Sykes, A.V.; Rodríguez, C. In vivo metabolism of unsaturated fatty acids in Octopus vulgaris hatchlings determined by incubation with 14C-labelled fatty acids added directly to seawater as protein complexes. Aquaculture 2014, 431, 28–33. [Google Scholar] [CrossRef]
- Agbaga, M.-P.; Brush, R.S.; Mandal, M.N.A.; Henry, K.; Elliott, M.H.; Anderson, R.E. Role of Stargardt-3 macular dystrophy protein (ELOVL4) in the biosynthesis of very long chain fatty acids. Proc. Natl. Acad. Sci. USA 2008, 105, 12843–12848. [Google Scholar] [CrossRef] [PubMed]
- Albertin, C.B.; Simakov, O.; Mitros, T.; Wang, Z.Y.; Pungor, J.R.; Edsinger-Gonzales, E.; Brenner, S.; Ragsdale, C.W.; Rokhsar, D.S. The octopus genome and the evolution of cephalopod neural and morphological novelties. Nature 2015, 524, 220–224. [Google Scholar] [CrossRef] [PubMed]
- Liu, H.; Guo, Z.; Zheng, H.; Wang, S.; Wang, Y.; Liu, W.; Zhang, G. Functional characterization of a Δ5-like fatty acyl desaturase and its expression during early embryogenesis in the noble scallop Chlamys nobilis Reeve. Mol. Biol. Rep. 2014, 41, 7437–7445. [Google Scholar] [CrossRef] [PubMed]
- Li, M.; Mai, K.; He, G.; Ai, Q.; Zhang, W.; Xu, W.; Wang, J.; Liufu, Z.; Zhang, Y.; Zhou, H. Characterization of Δ5 fatty acyl desaturase in abalone Haliotis discus hannai Ino. Aquaculture 2013, 416–417, 48–56. [Google Scholar] [CrossRef]
- Surm, J.M.; Prentis, P.J.; Pavasovic, A. Comparative analysis and distribution of Omega-3 LC-PUFA biosynthesis genes in marine molluscs. PLoS ONE 2015, 10, e0136301. [Google Scholar] [CrossRef] [PubMed]
- Liu, H.; Zang, H.; Zheng, H.; Wang, S.; Guo, Z.; Zhang, G. PUFA Biosynthesis pathway in marine scallop Chlamys nobilis Reeve. J. Agric. Food Chem. 2014, 62, 12384–12391. [Google Scholar] [CrossRef] [PubMed]
- Agbaga, M.-P.; Mandal, M.N.A.; Anderson, R.E. Retinal very long-chain PUFAs: New insights from studies on ELOVL4 protein. J. Lipid Res. 2010, 51, 1624–1642. [Google Scholar] [CrossRef] [PubMed]
- McMahon, A.; Jackson, S.N.; Woods, A.S.; Kedzierski, W. A Stargardt disease-3 mutation in the mouse Elovl4 gene causes retinal deficiency of C32–C36 acyl phosphatidylcholines. FEBS Lett. 2007, 581, 5459–5463. [Google Scholar] [CrossRef] [PubMed]
- Furland, N.E.; Oresti, G.M.; Antollini, S.S.; Venturino, A.; Maldonado, E.N.; Aveldaño, M.I. Very long-chain polyunsaturated fatty acids are the major acyl groups of sphingomyelins and ceramides in the head of mammalian spermatozoa. J. Biol. Chem. 2007, 282, 18151–18161. [Google Scholar] [CrossRef] [PubMed]
- Zadravec, D.; Tvrdik, P.; Guillou, H.; Haslam, R.; Kobayashi, T.; Napier, J.A.; Capecchi, M.R.; Jacobsson, A. ELOVL2 controls the level of n-6 28:5 and 30:5 fatty acids in testis, a prerequisite for male fertility and sperm maturation in mice. J. Lipid Res. 2011, 52, 245–255. [Google Scholar] [CrossRef] [PubMed]
- Zhukova, N.V. Lipid classes and fatty acid composition of the tropical nudibranch mollusks Chromodoris sp. and Phyllidia coelestis. Lipids 2007, 42, 1169–1175. [Google Scholar] [CrossRef] [PubMed]
- Zhukova, N.V. Lipids and fatty acids of nudibranch mollusks: Potential sources of bioactive compounds. Mar. Drugs 2014, 12, 4578–4592. [Google Scholar] [CrossRef] [PubMed]
- Hastings, N.; Agaba, M.; Tocher, D.R.; Leaver, M.J.; Dick, J.R.; Sargent, J.R.; Teale, A.J. A vertebrate fatty acid desaturase with ∆5 and ∆6 activities. Proc. Natl. Acad. Sci. USA 2001, 98, 14304–14309. [Google Scholar] [CrossRef] [PubMed]
- Lopes-Marques, M.; Ozório, R.; Amaral, R.; Tocher, D.R.; Monroig, Ó.; Castro, L.F.C. Molecular and functional characterization of a fads2 orthologue in the Amazonian teleost, Arapaima gigas. Comp. Biochem. Physiol. B 2017, 203, 84–91. [Google Scholar] [CrossRef] [PubMed]
- Folch, J.; Lees, N.; Sloane-Stanley, G.H. A simple method for the isolation and purification of total lipids from animal tissues. J. Biol. Chem. 1957, 226, 497–509. [Google Scholar] [PubMed]
- Destaillats, F.; Angers, P. One-step methodology for the synthesis of FA picolinyl esters from intact lipids. J. Am. Oil Chem. Soc. 2002, 79, 253–256. [Google Scholar] [CrossRef]
- Li, Y.; Monroig, Ó.; Zhang, L.; Wang, S.; Zheng, X.; Dick, J.R.; You, C.; Tocher, D.R. Vertebrate fatty acyl desaturase with Δ4 activity. Proc. Natl. Acad. Sci. USA 2010, 107, 16840–16845. [Google Scholar] [CrossRef] [PubMed]

| Fatty Acid | SC OLE1 | OV Scd |
|---|---|---|
| 16:0 | 23.5 ± 3.6 b | 59.3 ± 4.9 a |
| 16:1n-9 | 0.5 ± 0.4 | 0.7 ± 0.7 |
| 16:1n-7 | 35.0 ± 2.2 a | 4.5 ± 1.0 b |
| 18:0 | 8.0 ± 1.7 | 5.6 ± 1.3 |
| 18:1n-9 | 31.8 ± 2.5 | 29.8 ± 6.0 |
| 18:1n-7 | 1.1 ± 0.2 a | 0.0 ± 0.0 b |
| 18:1n-9/16:1n-7 | 0.9 ± 0.1 b | 6.8 ± 2.0 a |
| Fatty Acid | Control | OV Scd |
|---|---|---|
| 14:0 | 1.6 ± 0.2 a | 1.0 ± 0.1 b |
| 14:1n-5 | 0.5 ± 0.1 | 0.7 ± 0.1 |
| 16:0 | 25.9 ± 0.3 a | 22.2 ± 1.2 b |
| 16:1n-7 | 37.7 ± 0.8 a | 28.6 ± 3.3 b |
| 18:0 | 8.5 ± 0.3 a | 4.4 ± 0.9 b |
| 18:1n-9 | 24.1 ± 0.7 b | 40.9 ± 3.6 a |
| 18:1n-7 | 1.1 ± 0.1 | 1.1 ± 0.2 |
| 20:0 | 0.1 ± 0.0 | 0.1 ± 0.0 |
| 20:1n-11 | N.D. b | 0.4 ± 0.2 a |
| 22:0 | 0.1 ± 0.0 | 0.1 ± 0.0 |
| 22:1n-13 | N.D. b | 0.1 ± 0.0 a |
| FA Substrate | Product | % Conversion | Elongation |
|---|---|---|---|
| 18:3n-3 | 20:3n-3 | 2.8 | C18→22 |
| 22:3n-3 | 3.0 | C20→22 | |
| 18:2n-6 | 20:2n-6 | 1.1 | C18→22 |
| 22:2n-6 | 26.2 | C20→22 | |
| 18:4n-3 | 20:4n-3 | 1.0 | C18→20 |
| 18:3n-6 | 20:3n-6 | 0.8 | C18→20 |
| 20:5n-3 | 22:5n-3 | 1.9 | C20→24 |
| 24:5n-3 | 8.1 | C22→24 | |
| 20:4n-6 | 22:4n-6 | 1.0 | C20→24 |
| 24:4n-6 | 6.2 | C22→24 | |
| 22:5n-3 | 24:5n-3 | 4.8 | C22→32 |
| 26:5n-3 | 37.9 | C24→32 | |
| 28:5n-3 | 95.0 | C26→32 | |
| 30:5n-3 | 93.5 | C28→32 | |
| 32:5n-3 | 51.9 | C30→32 | |
| 22:4n-6 | 24:4n-6 | 3.6 | C22→32 |
| 26:4n-6 | 44.5 | C24→32 | |
| 28:4n-6 | 94.1 | C26→32 | |
| 30:4n-6 | 91.5 | C28→32 | |
| 32:4n-6 | 46.3 | C30→32 | |
| 22:6n-3 | 24:6n-3 | 0.7 | C22→24 |
| 24:5n-3 | 26:5n-3 | 1.4 | C24→34 |
| 28:5n-3 | 88.8 | C26→34 | |
| 30:5n-3 | 88.6 | C28→34 | |
| 32:5n-3 | 63.2 | C30→34 | |
| 34:5n-3 | 17.3 | C32→34 |
© 2017 by the authors. Licensee MDPI, Basel, Switzerland. This article is an open access article distributed under the terms and conditions of the Creative Commons Attribution (CC BY) license ( http://creativecommons.org/licenses/by/4.0/).
Share and Cite
Monroig, Ó.; De Llanos, R.; Varó, I.; Hontoria, F.; Tocher, D.R.; Puig, S.; Navarro, J.C. Biosynthesis of Polyunsaturated Fatty Acids in Octopus vulgaris: Molecular Cloning and Functional Characterisation of a Stearoyl-CoA Desaturase and an Elongation of Very Long-Chain Fatty Acid 4 Protein. Mar. Drugs 2017, 15, 82. https://doi.org/10.3390/md15030082
Monroig Ó, De Llanos R, Varó I, Hontoria F, Tocher DR, Puig S, Navarro JC. Biosynthesis of Polyunsaturated Fatty Acids in Octopus vulgaris: Molecular Cloning and Functional Characterisation of a Stearoyl-CoA Desaturase and an Elongation of Very Long-Chain Fatty Acid 4 Protein. Marine Drugs. 2017; 15(3):82. https://doi.org/10.3390/md15030082
Chicago/Turabian StyleMonroig, Óscar, Rosa De Llanos, Inmaculada Varó, Francisco Hontoria, Douglas R. Tocher, Sergi Puig, and Juan C. Navarro. 2017. "Biosynthesis of Polyunsaturated Fatty Acids in Octopus vulgaris: Molecular Cloning and Functional Characterisation of a Stearoyl-CoA Desaturase and an Elongation of Very Long-Chain Fatty Acid 4 Protein" Marine Drugs 15, no. 3: 82. https://doi.org/10.3390/md15030082
APA StyleMonroig, Ó., De Llanos, R., Varó, I., Hontoria, F., Tocher, D. R., Puig, S., & Navarro, J. C. (2017). Biosynthesis of Polyunsaturated Fatty Acids in Octopus vulgaris: Molecular Cloning and Functional Characterisation of a Stearoyl-CoA Desaturase and an Elongation of Very Long-Chain Fatty Acid 4 Protein. Marine Drugs, 15(3), 82. https://doi.org/10.3390/md15030082

